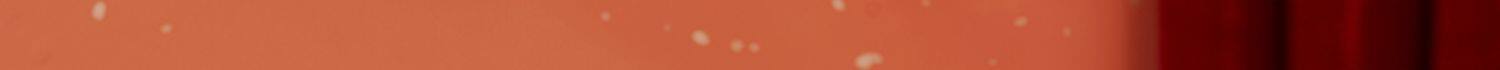

- Таобао
- Еда напиток инструмент
- Чашка / чашки / чайник
- Термосы
- 682170684507
Термос, красный вместительный и большой чайник из нержавеющей стали для домашнего использования

Цена: 2 957руб. (¥139.9)
Артикул: 682170684507
Вес товара: ~0.7 кг. Указан усредненный вес, который может отличаться от фактического. Не включен в цену, оплачивается при получении.
Описание товараPGRpdj48aW1nIHNyYz0iaHR0cHM6Ly9pbWcuYWxpY2RuLmNvbS9pbWdleHRyYS9pMS8xMTIyNTE0MTEyL08xQ04wMUpxamZ3cTFnRkxQTmVFYWtKXyEhMTEyMjUxNDExMi5qcGciPjwvZGl2PjxkaXY+PGltZyBzcmM9Imh0dHBzOi8vaW1nLmFsaWNkbi5jb20vaW1nZXh0cmEvaTMvMTEyMjUxNDExMi9PMUNOMDFna2JQNUIxZ0ZMUFVYSEk4OV8hITExMjI1MTQxMTIuanBnIj48L2Rpdj48ZGl2PjxpbWcgc3JjPSJodHRwczovL2ltZy5hbGljZG4uY29tL2ltZ2V4dHJhL2kxLzExMjI1MTQxMTIvTzFDTjAxTHBQcU5qMWdGTFBQTHlVQzhfISExMTIyNTE0MTEyLmpwZyI+PC9kaXY+PGRpdj48aW1nIHNyYz0iaHR0cHM6Ly9pbWcuYWxpY2RuLmNvbS9pbWdleHRyYS9pMS8xMTIyNTE0MTEyL08xQ04wMVVONDJSajFnRkxQYVdwam01XyEhMTEyMjUxNDExMi5qcGciPjwvZGl2PjxkaXY+PGltZyBzcmM9Imh0dHBzOi8vaW1nLmFsaWNkbi5jb20vaW1nZXh0cmEvaTQvMTEyMjUxNDExMi9PMUNOMDFwRUJKVXMxZ0ZMUFlZZkEwZF8hITExMjI1MTQxMTIuanBnIj48L2Rpdj48ZGl2PjxpbWcgc3JjPSJodHRwczovL2ltZy5hbGljZG4uY29tL2ltZ2V4dHJhL2kzLzExMjI1MTQxMTIvTzFDTjAxVmVaQ1NoMWdGTFBRN2ZRUDNfISExMTIyNTE0MTEyLmpwZyI+PC9kaXY+PGRpdj48aW1nIHNyYz0iaHR0cHM6Ly9pbWcuYWxpY2RuLmNvbS9pbWdleHRyYS9pMy8xMTIyNTE0MTEyL08xQ04wMTZuQlRlNDFnRkxQWFJ3OGJBXyEhMTEyMjUxNDExMi5qcGciPjwvZGl2PjxkaXY+PGltZyBzcmM9Imh0dHBzOi8vaW1nLmFsaWNkbi5jb20vaW1nZXh0cmEvaTQvMTEyMjUxNDExMi9PMUNOMDExd29wYUoxZ0ZMUFNVOFFnOF8hITExMjI1MTQxMTIuanBnIj48L2Rpdj48ZGl2PjxpbWcgc3JjPSJodHRwczovL2ltZy5hbGljZG4uY29tL2ltZ2V4dHJhL2kzLzExMjI1MTQxMTIvTzFDTjAxQkdFN0FsMWdGTFBVNmlMWU5fISExMTIyNTE0MTEyLmpwZyI+PC9kaXY+PGRpdj48aW1nIHNyYz0iaHR0cHM6Ly9pbWcuYWxpY2RuLmNvbS9pbWdleHRyYS9pMy8xMTIyNTE0MTEyL08xQ04wMVRuVjVBbTFnRkxQYk5ZbVpRXyEhMTEyMjUxNDExMi5qcGciPjwvZGl2PjxkaXY+PGltZyBzcmM9Imh0dHBzOi8vaW1nLmFsaWNkbi5jb20vaW1nZXh0cmEvaTEvMTEyMjUxNDExMi9PMUNOMDEybHlLWW0xZ0ZMUFhSdWY4UF8hITExMjI1MTQxMTIuanBnIj48L2Rpdj48ZGl2PjxpbWcgc3JjPSJodHRwczovL2ltZy5hbGljZG4uY29tL2ltZ2V4dHJhL2kxLzExMjI1MTQxMTIvTzFDTjAxbVROTmdVMWdGTFBhV3EwWjBfISExMTIyNTE0MTEyLmpwZyI+PC9kaXY+PGRpdj48aW1nIHNyYz0iaHR0cHM6Ly9pbWcuYWxpY2RuLmNvbS9pbWdleHRyYS9pMS8xMTIyNTE0MTEyL08xQ04wMUg3WEV4djFnRkxQWktwbHYzXyEhMTEyMjUxNDExMi5qcGciPjwvZGl2PjxkaXY+PGltZyBzcmM9Imh0dHBzOi8vaW1nLmFsaWNkbi5jb20vaW1nZXh0cmEvaTEvMTEyMjUxNDExMi9PMUNOMDFyMUliQ3AxZ0ZMUGFXcHNGVl8hITExMjI1MTQxMTIuanBnIj48L2Rpdj48ZGl2PjxpbWcgc3JjPSJodHRwczovL2ltZy5hbGljZG4uY29tL2ltZ2V4dHJhL2kyLzExMjI1MTQxMTIvTzFDTjAxWXVoQnBLMWdGTFBXaFQ3eU5fISExMTIyNTE0MTEyLmpwZyI+PC9kaXY+PGRpdj48aW1nIHNyYz0iaHR0cHM6Ly9pbWcuYWxpY2RuLmNvbS9pbWdleHRyYS9pMy8xMTIyNTE0MTEyL08xQ04wMWJpOUhwVjFnRkxQWFJ3YmhzXyEhMTEyMjUxNDExMi5qcGciPjwvZGl2PjxkaXY+PGltZyBzcmM9Imh0dHBzOi8vaW1nLmFsaWNkbi5jb20vaW1nZXh0cmEvaTQvMTEyMjUxNDExMi9PMUNOMDFka2Q1SncxZ0ZMUFNVOGhJNl8hITExMjI1MTQxMTIuanBnIj48L2Rpdj48ZGl2PjxpbWcgc3JjPSJodHRwczovL2ltZy5hbGljZG4uY29tL2ltZ2V4dHJhL2kzLzExMjI1MTQxMTIvTzFDTjAxdnA5UVZ2MWdGTFBTSm1QeXNfISExMTIyNTE0MTEyLmpwZyI+PC9kaXY+PGRpdj48aW1nIHNyYz0iaHR0cHM6Ly9pbWcuYWxpY2RuLmNvbS9pbWdleHRyYS9pMy8xMTIyNTE0MTEyL08xQ04wMTFDa0QxZDFnRkxQWVlmOXllXyEhMTEyMjUxNDExMi5qcGciPjwvZGl2PjxkaXY+PGltZyBzcmM9Imh0dHBzOi8vaW1nLmFsaWNkbi5jb20vaW1nZXh0cmEvaTIvMTEyMjUxNDExMi9PMUNOMDFJN2RLYzYxZ0ZMUFdoVmdBWV8hITExMjI1MTQxMTIuanBnIj48L2Rpdj48ZGl2PjxpbWcgc3JjPSJodHRwczovL2ltZy5hbGljZG4uY29tL2ltZ2V4dHJhL2kzLzExMjI1MTQxMTIvTzFDTjAxTjlpQnpBMWdGTFBKQmtCNlBfISExMTIyNTE0MTEyLmpwZyI+PC9kaXY+PGRpdj48aW1nIHNyYz0iaHR0cHM6Ly9pbWcuYWxpY2RuLmNvbS9pbWdleHRyYS9pNC8xMTIyNTE0MTEyL08xQ04wMXd1bkdUTDFnRkxQU0ppM1kxXyEhMTEyMjUxNDExMi5qcGciPjwvZGl2PjxkaXY+PGltZyBzcmM9Imh0dHBzOi8vaW1nLmFsaWNkbi5jb20vaW1nZXh0cmEvaTMvMTEyMjUxNDExMi9PMUNOMDEycDdPMUQxZ0ZMUGFXcFRLYV8hITExMjI1MTQxMTIuanBnIj48L2Rpdj48ZGl2PjxpbWcgc3JjPSJodHRwczovL2ltZy5hbGljZG4uY29tL2ltZ2V4dHJhL2kyLzExMjI1MTQxMTIvTzFDTjAxdTE5dFhWMWdGTFBUNUVyTE5fISExMTIyNTE0MTEyLmpwZyI+PC9kaXY+PGRpdj48aW1nIHNyYz0iaHR0cHM6Ly9pbWcuYWxpY2RuLmNvbS9pbWdleHRyYS9pMS8xMTIyNTE0MTEyL08xQ04wMWU2UW9EdzFnRkxQTnc4WGpYXyEhMTEyMjUxNDExMi5qcGciPjwvZGl2PjxkaXY+PGltZyBzcmM9Imh0dHBzOi8vaW1nLmFsaWNkbi5jb20vaW1nZXh0cmEvaTEvMTEyMjUxNDExMi9PMUNOMDFoMFNjSDAxZ0ZMUE53QTVLaV8hITExMjI1MTQxMTIuanBnIj48L2Rpdj48ZGl2PjxpbWcgc3JjPSJodHRwczovL2ltZy5hbGljZG4uY29tL2ltZ2V4dHJhL2k0LzExMjI1MTQxMTIvTzFDTjAxbkhyMGJGMWdGTFBhV3BvNnJfISExMTIyNTE0MTEyLmpwZyI+PC9kaXY+PGRpdj48aW1nIHNyYz0iaHR0cHM6Ly9pbWcuYWxpY2RuLmNvbS9pbWdleHRyYS9pMy8xMTIyNTE0MTEyL08xQ04wMXNNTHl0QjFnRkxQVnBBd0xqXyEhMTEyMjUxNDExMi5qcGciPjwvZGl2PjxkaXY+PGltZyBzcmM9Imh0dHBzOi8vaW1nLmFsaWNkbi5jb20vaW1nZXh0cmEvaTEvMTEyMjUxNDExMi9PMUNOMDFKanpST3QxZ0ZMUEpCaVZBMV8hITExMjI1MTQxMTIuanBnIj48L2Rpdj48ZGl2PjxpbWcgc3JjPSJodHRwczovL2ltZy5hbGljZG4uY29tL2ltZ2V4dHJhL2kxLzExMjI1MTQxMTIvTzFDTjAxVTVORXE5MWdGTFBKQmhRYVdfISExMTIyNTE0MTEyLmpwZyI+PC9kaXY+PGRpdj48aW1nIHNyYz0iaHR0cHM6Ly9pbWcuYWxpY2RuLmNvbS9pbWdleHRyYS9pNC8xMTIyNTE0MTEyL08xQ04wMVVvb0p1ZzFnRkxQVnBCTExxXyEhMTEyMjUxNDExMi5qcGciPjwvZGl2PjxkaXY+PGltZyBzcmM9Imh0dHBzOi8vaW1nLmFsaWNkbi5jb20vaW1nZXh0cmEvaTMvMTEyMjUxNDExMi9PMUNOMDFmdUs5anUxZ0ZMUE53N3dGTl8hITExMjI1MTQxMTIuanBnIj48L2Rpdj48ZGl2PjxpbWcgc3JjPSJodHRwczovL2ltZy5hbGljZG4uY29tL2ltZ2V4dHJhL2k0LzExMjI1MTQxMTIvTzFDTjAxVVJHSXBBMWdGTFBaS3F5aldfISExMTIyNTE0MTEyLmpwZyI+PC9kaXY+PGRpdj48aW1nIHNyYz0iaHR0cHM6Ly9pbWcuYWxpY2RuLmNvbS9pbWdleHRyYS9pMS8xMTIyNTE0MTEyL08xQ04wMWswc1JwaDFnRkxQWFJ4MGJYXyEhMTEyMjUxNDExMi5qcGciPjwvZGl2PjxkaXY+PGltZyBzcmM9Imh0dHBzOi8vaW1nLmFsaWNkbi5jb20vaW1nZXh0cmEvaTMvMTEyMjUxNDExMi9PMUNOMDFtNmhSQkUxZ0ZMUFpLcXViSl8hITExMjI1MTQxMTIuanBnIj48L2Rpdj48ZGl2PjxpbWcgc3JjPSJodHRwczovL2ltZy5hbGljZG4uY29tL2ltZ2V4dHJhL2k0LzExMjI1MTQxMTIvTzFDTjAxcEo4alJPMWdGTFBUNUZHSWtfISExMTIyNTE0MTEyLmpwZyI+PC9kaXY+PGRpdj48aW1nIHNyYz0iaHR0cHM6Ly9pbWcuYWxpY2RuLmNvbS9pbWdleHRyYS9pMS8xMTIyNTE0MTEyL08xQ04wMXZnOWRCWDFnRkxQWFJ3WFgwXyEhMTEyMjUxNDExMi5qcGciPjwvZGl2PjxkaXY+PGltZyBzcmM9Imh0dHBzOi8vaW1nLmFsaWNkbi5jb20vaW1nZXh0cmEvaTEvMTEyMjUxNDExMi9PMUNOMDFCVlBYQVoxZ0ZMUFVYRUgxel8hITExMjI1MTQxMTIuanBnIj48L2Rpdj48ZGl2PjxpbWcgc3JjPSJodHRwczovL2ltZy5hbGljZG4uY29tL2ltZ2V4dHJhL2k0LzExMjI1MTQxMTIvTzFDTjAxUldheklwMWdGTFBKQmpORHJfISExMTIyNTE0MTEyLmpwZyI+PC9kaXY+PGRpdj48aW1nIHNyYz0iaHR0cHM6Ly9pbWcuYWxpY2RuLmNvbS9pbWdleHRyYS9pNC8xMTIyNTE0MTEyL08xQ04wMTBaT04xVjFnRkxQWVlmVWtjXyEhMTEyMjUxNDExMi5qcGciPjwvZGl2PjxkaXY+PGltZyBzcmM9Imh0dHBzOi8vaW1nLmFsaWNkbi5jb20vaW1nZXh0cmEvaTIvMTEyMjUxNDExMi9PMUNOMDFFdXNGV2kxZ0ZMUFQ1Rjgwa18hITExMjI1MTQxMTIuanBnIj48L2Rpdj48ZGl2PjxpbWcgc3JjPSJodHRwczovL2ltZy5hbGljZG4uY29tL2ltZ2V4dHJhL2kyLzExMjI1MTQxMTIvTzFDTjAxZTJubHZ6MWdGTFBKQmpFczRfISExMTIyNTE0MTEyLmpwZyI+PC9kaXY+PGRpdj48aW1nIHNyYz0iaHR0cHM6Ly9pbWcuYWxpY2RuLmNvbS9pbWdleHRyYS9pNC8xMTIyNTE0MTEyL08xQ04wMUVhY3NXVTFnRkxQWktxaTdBXyEhMTEyMjUxNDExMi5qcGciPjwvZGl2PjxkaXY+PGltZyBzcmM9Imh0dHBzOi8vaW1nLmFsaWNkbi5jb20vaW1nZXh0cmEvaTQvMTEyMjUxNDExMi9PMUNOMDFxcmxZUWExZ0ZMUFNVN0RxUl8hITExMjI1MTQxMTIuanBnIj48L2Rpdj48ZGl2PjxpbWcgc3JjPSJodHRwczovL2ltZy5hbGljZG4uY29tL2ltZ2V4dHJhL2kyLzExMjI1MTQxMTIvTzFDTjAxNEdtYnpTMWdGTFBhV3NIeEJfISExMTIyNTE0MTEyLmpwZyI+PC9kaXY+PGRpdj48aW1nIHNyYz0iaHR0cHM6Ly9pbWcuYWxpY2RuLmNvbS9pbWdleHRyYS9pMy8xMTIyNTE0MTEyL08xQ04wMW9seHFNUzFnRkxQVVhGb2RzXyEhMTEyMjUxNDExMi5qcGciPjwvZGl2PjxkaXY+PGltZyBzcmM9Imh0dHBzOi8vaW1nLmFsaWNkbi5jb20vaW1nZXh0cmEvaTIvMTEyMjUxNDExMi9PMUNOMDEyczdFSDgxZ0ZMUFQ1RVNSSF8hITExMjI1MTQxMTIuanBnIj48L2Rpdj48ZGl2PjxpbWcgc3JjPSJodHRwczovL2ltZy5hbGljZG4uY29tL2ltZ2V4dHJhL2kxLzExMjI1MTQxMTIvTzFDTjAxOU5QYm42MWdGTFBVWERzMzdfISExMTIyNTE0MTEyLmpwZyI+PC9kaXY+PGRpdj48aW1nIHNyYz0iaHR0cHM6Ly9pbWcuYWxpY2RuLmNvbS9pbWdleHRyYS9pMy8xMTIyNTE0MTEyL08xQ04wMWNTQ05BZDFnRkxQYk5ZYTZlXyEhMTEyMjUxNDExMi5qcGciPjwvZGl2PjxkaXY+PGltZyBzcmM9Imh0dHBzOi8vaW1nLmFsaWNkbi5jb20vaW1nZXh0cmEvaTQvMTEyMjUxNDExMi9PMUNOMDFKYW5ON3gxZ0ZMUFBMeTlPSV8hITExMjI1MTQxMTIuanBnIj48L2Rpdj48ZGl2PjxpbWcgc3JjPSJodHRwczovL2ltZy5hbGljZG4uY29tL2ltZ2V4dHJhL2kxLzExMjI1MTQxMTIvTzFDTjAxNXIyYlJJMWdGTFBKQmhVbnpfISExMTIyNTE0MTEyLmpwZyI+PC9kaXY+PGRpdj48aW1nIHNyYz0iaHR0cHM6Ly9pbWcuYWxpY2RuLmNvbS9pbWdleHRyYS9pMy8xMTIyNTE0MTEyL08xQ04wMWFBa2puTjFnRkxQYVdyY0tmXyEhMTEyMjUxNDExMi5qcGciPjwvZGl2Pg==
Продавец:苏泊尔载亿专卖店
Адрес:Шанхай
Рейтинг:

Всего отзывов:0
Положительных:0
Добавить в корзину
- Информация о товаре
- Фотографии